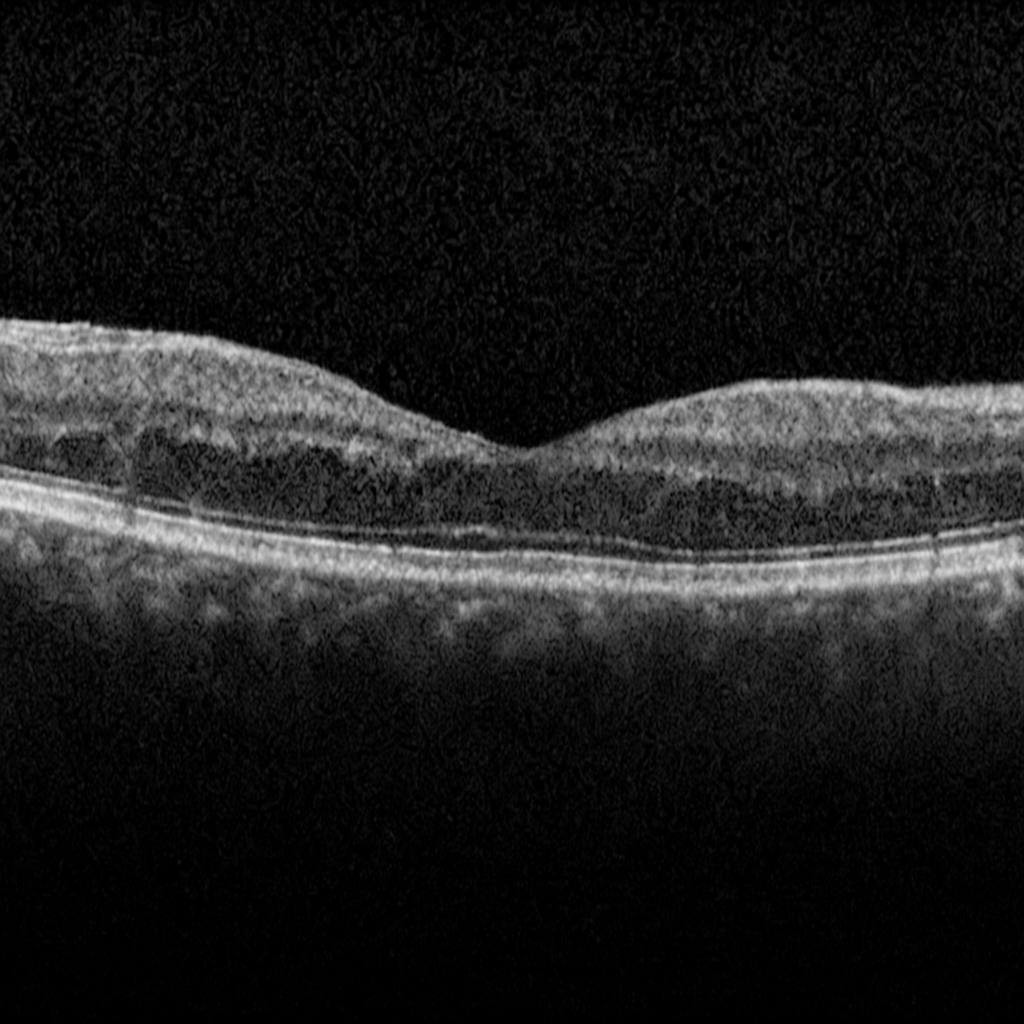

About Epiretinal Membranes
An epiretinal membrane (ERM) is a thin layer of scar-like tissue that forms on the surface of the retina, usually over the macula (the area responsible for central vision). It can cause the retina to wrinkle or contract, leading to blurred or distorted vision.
Frequently Asked Questions
What causes an epiretinal membrane?
ERM usually develops with age as the vitreous gel inside the eye naturally changes. It may also occur after:
Retinal tears or detachments
Retinal vascular conditions (like diabetic retinopathy or retinal vein occlusion)
Eye inflammation or trauma
What symptoms does ERM cause?
Common symptoms include:
Blurry or cloudy central vision
Straight lines appearing wavy (metamorphopsia)
Difficulty reading fine print
A gray or blank spot in central vision (less common)
Is an epiretinal membrane dangerous?
ERM does not cause blindness and usually progresses slowly. However, it can interfere with daily activities like reading, driving, or recognizing faces. Severe cases may significantly reduce vision quality if untreated.
Do all patients with ERM need treatment?
No. Many patients have mild ERM with little to no symptoms and do not need treatment. Regular monitoring with eye exams and OCT scans is often enough.
What treatments are available?
Observation – For mild or stable ERM without major vision problems.
Vitrectomy surgery – For significant vision loss or distortion. During this surgery, the vitreous gel is removed and the epiretinal membrane is carefully peeled from the retina to improve vision.
How successful is surgery?
Most patients notice an improvement in vision and reduction in distortion after surgery. Vision may not return to “perfect” but usually improves enough for better daily function. Recovery can take several months.